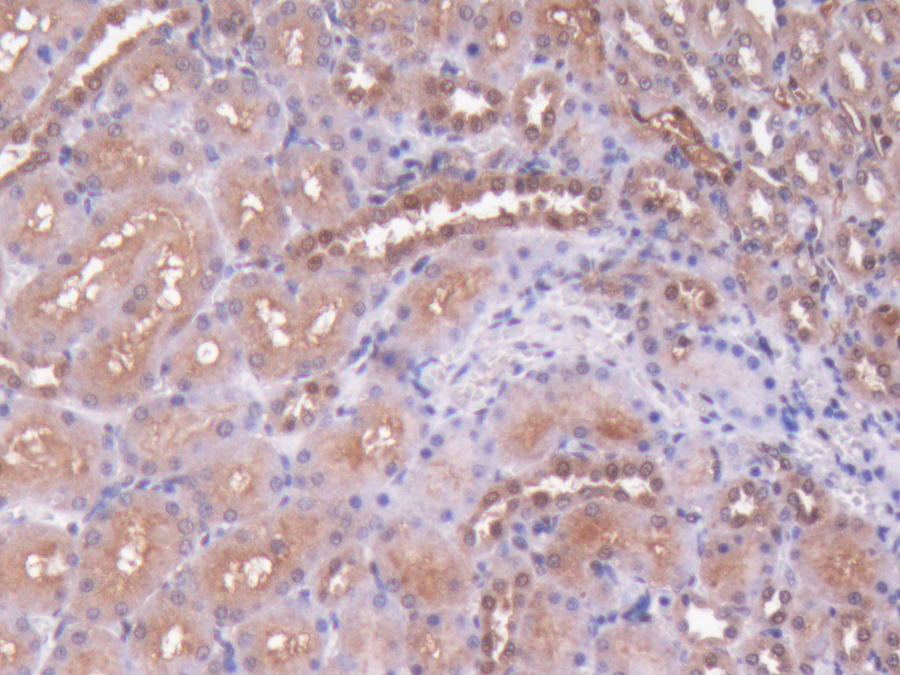

Biotin-Linked Polyclonal Antibody to S100 Calcium Binding Protein (S100)
S100-A1; S100A1; S100-Alpha; S-100 Protein; S-100 protein subunit alpha; S-100 protein alpha chain
- Product No.LAA012Ra71
- Organism SpeciesRattus norvegicus (Rat) Same name, Different species.
- SourceAntibody labeling
- Ig Type IgG
- PurificationAntigen-specific affinity chromatography followed by Protein A affinity chromatography
- LabelBiotin
- Original Antibody PAA012Ra01-Polyclonal Antibody to S100 Calcium Binding Protein (S100)
- Buffer Formulation0.01M PBS, pH7.4, containing 0.05% Proclin-300, 50% glycerol.
- TraitsLiquid
- Concentration500µg/mL
- Organism Species Moren/a
- ApplicationsIHC
If the antibody is used in flow cytometry, please check FCM antibodies. - Downloadn/a
- UOM 20µl100µl 200µl 1ml 10ml
- FOB
US$ 113
US$ 263
US$ 376
US$ 940
US$ 3760
For more details, please contact local distributors!
SPECIFITY
The antibody is a rabbit polyclonal antibody raised against S100. It has been selected for its ability to recognize S100 in immunohistochemical staining and western blotting.
USAGE
Immunohistochemistry: 5-20µg/mL;
Optimal working dilutions must be determined by end user.
STORAGE
Store at 4°C for frequent use. Stored at -20°C in a manual defrost freezer for two year without detectable loss of activity. Avoid repeated freeze-thaw cycles.
STABILITY
The thermal stability is described by the loss rate. The loss rate was determined by accelerated thermal degradation test, that is, incubate the protein at 37°C for 48h, and no obvious degradation and precipitation were observed. The loss rate is less than 5% within the expiration date under appropriate storage condition.
GIVEAWAYS
INCREMENT SERVICES
-
 Protein A/G Purification Column
Protein A/G Purification Column
-
 Staining Solution for Cells and Tissue
Staining Solution for Cells and Tissue
-
 Positive Control for Antibody
Positive Control for Antibody
-
 Tissue/Sections Customized Service
Tissue/Sections Customized Service
-
 Phosphorylated Antibody Customized Service
Phosphorylated Antibody Customized Service
-
 Western Blot (WB) Experiment Service
Western Blot (WB) Experiment Service
-
 Immunohistochemistry (IHC) Experiment Service
Immunohistochemistry (IHC) Experiment Service
-
 Immunocytochemistry (ICC) Experiment Service
Immunocytochemistry (ICC) Experiment Service
-
 Flow Cytometry (FCM) Experiment Service
Flow Cytometry (FCM) Experiment Service
-
 Immunoprecipitation (IP) Experiment Service
Immunoprecipitation (IP) Experiment Service
-
 Immunofluorescence (IF) Experiment Service
Immunofluorescence (IF) Experiment Service
-
 Buffer
Buffer
-
 DAB Chromogen Kit
DAB Chromogen Kit
-
 SABC Kit
SABC Kit
-
 Real Time PCR Experimental Service
Real Time PCR Experimental Service
| Magazine | Citations |
| Brain Research | Vasoactive intestinal peptide protects against ischemic brain damage induced by focal cerebral ischemia in rats ScienceDirect: S0006899311008663 |
| J Exp Neurosci | A New Technique for Collection of Cerebrospinal Fluid in Rat Pups PubMed: 26056488 |
| PLoS One | Regulation of Nutritional Metabolism in Transition Dairy Cows: Energy Homeostasis and Health in Response to Post-Ruminal Choline and Methionine pubmed:27501393 |
| brain research | Ellagic acid exerts protective effect in intrastriatal 6-hydroxydopamine rat model of Parkinson's disease: Possible involvement of ERβ/Nrf2/HO-1 signaling. pubmed:28238669 |
| КиберЛенинка | Levels of neurotropic autoantibodies in patients with schizophrenia article:n |
| Biomed Research International | Epigallocatechin-3-Gallate Reduces Neuronal Apoptosis in Rats after Middle Cerebral Artery Occlusion Injury via PI3K/AKT/eNOS Signaling Pathway Pubmed:29770336 |
| Metabolic Brain Disease | Trigonelline protects hippocampus against intracerebral Aβ (1–40) as a model of Alzheimer's disease in the rat: insights into underlying mechanisms Pubmed: 30421246 |
| ВОЗМОЖНОСТЬ ПРОГНОЗИРОВАНИЯ ОСТРОЙ НЕСПЕЦИФИЧЕСКОЙ БОЛИ В НИЖНЕЙ ЧАСТИ СПИНЫ С ИСПОЛЬЗОВАНИЕМ СЫВОРОТОЧНЫХ … | |
| ВЛИЯНИЕ ХРОНИЧЕСКОГО ВВЕДЕНИЯ НЕЙРОЛЕПТИКОВ НА УРОВНИ НЕЙРОСПЕЦИФИЧЕСКИХ АУТОАНТИТЕЛ В КРОВИ У КРЫС |